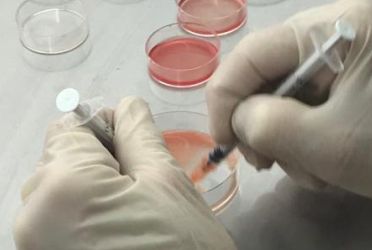

Većina infertilnih parova ima više od jednog uzroka neplodnosti, stoga je potrebno da oba partnera posjete doktora. Ponekad je potrebno uraditi bezbroj testova da se utvrdi uzrok infertiliteta. U nekim slučajevima uzrok se ne otkrije.
Postavljanje dijagnoze muškog infertiliteta uključuje:
Fizikalni pregled i istorija bolesti
Ovo uključuje pregled genitalija te postavljanje pitanja u vezi nasljednih bolesti, hroničnih zdravstvenih problema, bolesti, povreda ili hirurških zahvata koji mogu utjecati na fertilitet. Također se postavljaju pitanja u vezi seksualnih navika i seksulnog razvoja tokom puberteta.
Spermiogram
Analiza sperme također nazvana spermiogram ili seminogram evaluira određene karakteristike sperme i sadržaj sjemene tekućine.
Radi se radi evaluacije muške neplodnosti, bilo u cilju trudnoće ili radi evaluacije uspjeha vazektomije.
U zavisnosti od metode ispitivanja mogu biti evaluirane samo pojedine karakteristike ili daleko veće analiza sperme sa više karakteristika. Tehnike prikupljanja i precizan mehanizam ispitivanja mogu utjecati na rezultat analize sperme.
Vaš doktor može zahtjevati dodatne testove u cilju identifikacije uzroka infertiliteta.
Ovo uključuje:
- Ultrazvuk skrotuma.
Ova pretraga može pomoći da se utvrdi postojanje varikokele ili drugih problema u testisima ili u drugim strukturama. - Transrektalni ultrazvuk
Omogućava da se pregleda prostata i utvrdi postojanje blokade tubula koji sadrže sjemenu tekućinu. - Hormonalna analiza
Hormoni nastali u hipofizi, hipotalamusu i testisima igraju važnu ulogu u seksualnom razvoju i produkciji sperme. Poremećaji u drugim hormonalnim ili organskim sistemima također mogu doprinjeti infertilitetu. Krvni testovi mjere nivo testosterona i drugih hormona.
Važne hemijske supstance nazvane hormoni kontrolišu produkciju sperme. One također utječu na interes za seks i sposobnost za sekusalni odnos. Previše ovih hormona ili premalo ovih hormona može prouzrokovati probleme sa produkcijom sperme ili nemogućnost seksualnog odnosa.
Dva najvažnija hormona su FSH (folikulostimulirajući hormon) i testosteron. Ukoliko je potrebno provjeriće se nivo i luteinizarajućeg hormona (LH), estradiola, i prolaktina. Tireoidni hormoni koji prije nisu smatrani da utiču na spermatogenezu i muški fertilitet, sada su priznati kao značajan faktor u spermatogenezi.
Inhibin B je testikularni polipeptidni hormon odgovoran za negativnu povratnu vezu regulacije hipofizne sekrecije FSH kod muškaraca. Inhibin B se smatra markerom spermatogeneze i subfertilni muškarci uopšteno imaju smanjen ili nedektabilan nivo inhibina B sa izuzetkom kod muškaraca sa obstruktivnom formom azoospermije ili spermatogenog zastoja na nivou spermatocita, koji imaju normalan nivo inhibina B. - Post-ejakulacijska analiza urina.
Spermatozoidi u urinu upućuju da spermatozoidi putuju nazad ka mokraćnom mjehuru umjesto u penis tokom ejakulacije (retrogradna ejakulacija). - Genetska analiza
Ukoliko je broj spermatozoida veoma nizak moguće je da je uzrok u genima. Krvni test može otkriti da li postoje promjene na Y hromozomu kao znak genetske abnormalnosti. Genetsko testiranje može biti zatraženo da se utvrdi postojanje različitih nasljednih ili stečenih sindroma. - Biopsija testisa
Uključuje uzorkovanje tkiva testisa uz pomoć igle. Ukoliko rezultat biopsije testisa ukaže na urednu spermatogenezu onda je problem u blokadi ili drugim problemima transporta spermatozoida. - Specijalizirani funkcionalni test spermatozoida
Brojni testovi se mogu raditi da se procjeni kako će spermatozoidi preživjeti nakon ejakulacije, kako će penetrirati u jajašce i da li će biti problema u toku spajanja za jajašce. Uopšteno ovi testovi se rijetko izvode i često ne utiču značajno na preporuke za izmjenu tretmana.